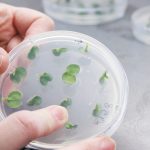
Edición genética para mejorar los alimentos

En la Unión Europea, el Reglamento 1169/2011 sobre la información alimentaria facilitada al consumidor, obliga a hacer constar en el etiquetado de los productos alimenticios los posibles alérgenos que puedan contener. Alergias ya sabemos que hay muchas y el número de personas afectadas parece que va en aumento. Pero sólo son 14 los alérgenos de declaración obligatoria, y es lo que vamos a ver a continuación.
El objetivo es ofrecer a los consumidores una información clara y precisa que garantice una alimentación segura y adecuada según sus necesidades o restricciones alimentarias, y en base a la prevalencia de las alergias, a los riesgos de las reacciones alérgicas graves y al amplio uso de algunos ingredientes considerados alérgenos en la producción de alimentos procesados, se han seleccionado los catorce alérgenos mencionados.
A continuación podéis ver cuáles son los alérgenos de obligada declaración en los productos alimenticios según rige en el Reglamento (UE) 1169/2011 sobre la información alimentaria facilitada al consumidor:

1. Cereales que contengan gluten, a saber: trigo, centeno, cebada, avena, espelta, kamut o sus variedades híbridas y productos derivados, salvo:
a) jarabes de glucosa a base de trigo, incluida la dextrosa (1);
b) maltodextrinas a base de trigo (1);
c) jarabes de glucosa a base de cebada;
d) cereales utilizados para hacer destilados alcohólicos, incluido el alcohol etílico de origen agrícola.2. Crustáceos y productos a base de crustáceos.
3. Huevos y productos a base de huevo.
4. Pescado y productos a base de pescado, salvo:
a) gelatina de pescado utilizada como soporte de vitaminas o preparados de carotenoides;
b) gelatina de pescado o ictiocola utilizada como clarificante en la cerveza y el vino.5. Cacahuetes y productos a base de cacahuetes.
6. Soja y productos a base de soja, salvo:
a) aceite y grasa de semilla de soja totalmente refinados (1);
b) tocoferoles naturales mezclados (E306), d-alfa tocoferol natural, acetato de d-alfa tocoferol natural y succinato de d-alfa tocoferol natural derivados de la soja;
c) fitosteroles y ésteres de fitosterol derivados de aceites vegetales de soja;
d) ésteres de fitostanol derivados de fitosteroles de aceite de semilla de soja.7. Leche y sus derivados (incluida la lactosa), salvo:
a) lactosuero utilizado para hacer destilados alcohólicos, incluido el alcohol etílico de origen agrícola;
b) lactitol.8. Frutos de cáscara, es decir: almendras (Amygdalus communis L.), avellanas (Corylus avellana), nueces (Juglans regia), anacardos (Anacardium occidentale), pacanas [Carya illinoensis (Wangenh.) K. Koch], nueces de Brasil (Bertholletia excelsa), alfóncigos (Pistacia vera), nueces macadamia o nueces de Australia (Macadamia ternifolia) y productos derivados, salvo los frutos de cáscara utilizados para hacer destilados alcohólicos, incluido el alcohol etílico de origen agrícola.
9. Apio y productos derivados.
10. Mostaza y productos derivados.
11. Granos de sésamo y productos a base de granos de sésamo.
12. Dióxido de azufre y sulfitos en concentraciones superiores a 10 mg/kg o 10 mg/litro en términos de SO2 total, para los productos listos para el consumo o reconstituidos conforme a las instrucciones del fabricante.
13. Altramuces y productos a base de altramuces.
14. Moluscos y productos a base de moluscos.
Estos alérgenos deben ser declarados y constar visiblemente en la lista de ingredientes de los productos alimenticios, ya sea indicando el nombre del alérgeno o utilizando una tipografía o formato específico. Esto es fundamental para garantizar la salud pública, permitiendo que las personas con alergias alimentarias puedan identificar fácilmente los productos que pueden afectar su salud.
Te puede interesar leer:
Existe un gran número de alérgenos no declarados en los alimentos envasados
Guía Etiquetado Precautorio de Alérgenos (EPA)
Uso innecesario de “puede contener” en las etiquetas alimentarias